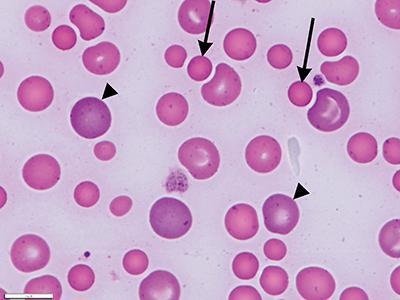
Состояние, при котором в крови определяются эритроциты аномальных размеров, называется анизоцитозом

Воспользуйтесь поиском по сайту:
RDW в анализе крови – что это такое?
Содержание статьи:
Ширина распределения эритроцитов по объему (RDW, от red cells distribution width) – это эритроцитарный индекс, который позволяет определить разнородность клеточного объема в периферической крови.
Появление в крови различающихся по объему эритроцитов называется анизоцитозом, степень которого позволяет определить индекс RDW.
Эритроциты, их функции в организме, основные показатели
Эритроциты, или красные кровяные тельца (RBC, red blood cells), – это красные кровяные тельца, клетки крови двояковогнутой дисковидной формы, лишенные ядра. Форма эритроцита позволяет клетке деформироваться при продвижении через кровеносные сосуды малого калибра. Основной функцией эритроцитов является транспорт кислорода от легких к тканям и органам, а от них – углекислого газа в легкие. Эритроциты образуются в костном мозге и разрушаются в селезенке, средний срок жизни клеток составляет 120 суток. У новорожденных размер эритроцитов больше, чем у взрослых.
Состояние, при котором в крови определяются эритроциты аномальных размеров, называется анизоцитозом
Состояние, при котором в крови определяются эритроциты аномальных размеров, называется анизоцитозомФизиологическое увеличение количества эритроцитов наблюдается у детей первых дней жизни, при частых стрессах, интенсивных физических нагрузках, недостаточном питании или голодании, при длительном пережатии конечности жгутом во время взятия крови для проведения анализа крови. Физиологическое уменьшение количества красных кровяных телец происходит сразу после еды, в промежуток времени между 17:00 и 07:00 и в случае взятия крови у пациента в положении лежа.
В крови, помимо нормальных эритроцитов, могут присутствовать клетки, отличающиеся размерами – более крупные (макроциты) или мелкие (микроциты) красные кровяные тельца. Состояние, при котором в крови находится более 50% макроцитов, называется макроцитозом. При наличии 30–50% микроцитов диагностируется микроцитоз. Появление в крови различающихся по объему эритроцитов называется анизоцитозом, степень которого позволяет определить индекс RDW.
К эритроцитарным индексам в общем анализе крови, помимо RDW, относятся MCV (средний объем эритроцита), MCH (среднее содержание гемоглобина в эритроците), MCHC (средняя концентрация гемоглобина в эритроцитарной массе).
Эритроцитарные индексы определяются в ходе общего (клинического) анализа крови. Подсчет осуществляется при помощи автоматического гематологического анализатора, по соответствующим формулам и/или в окрашенном мазке крови под микроскопом при подсчете лейкоцитарной формулы. К эритроцитарным индексам в общем анализе крови, помимо RDW, относятся MCV (средний объем эритроцита), MCH (среднее содержание гемоглобина в эритроците), MCHC (средняя концентрация гемоглобина в эритроцитарной массе).
Как правильно подготовиться и сдать общий анализ крови
Общий анализ крови – базовое исследование, которое проводят по следующим показаниям:
- профилактика, с целью раннего выявления вероятных патологий;
- диагностика заболеваний;
- контроль проводимой терапии;
- перед оперативными вмешательствами;
- наблюдение за ходом беременности.
Общий анализ крови включает в себя подсчет количества клеток крови (эритроцитов, лейкоцитов, тромбоцитов), определение концентрации гемоглобина, уровня гематокрита, эритроцитарных и тромбоцитарных индексов, скорости оседания эритроцитов. В развернутый анализ крови входит подсчет лейкоцитарной формулы.
В профилактических целях следует сдавать общий анализ крови ежегодно. Лицам из групп риска (при отягощенной наследственности, наличии хронических заболеваний, производственных вредностей, во время беременности и т. д.) может потребоваться более частое проведение данного исследования – 2 раза в год, 1 раз в 3 месяца, а иногда чаще.
Кровь для развернутого общего анализа, который включает определение эритроцитарных индексов, в том числе показателя RDW, обычно берут из вены. В некоторых случаях может производиться забор капиллярной крови из пальца. Кровь сдается утром натощак, по меньшей мере через восемь часов после последнего приема пищи. Перед сдачей крови следует избегать психических и физических перегрузок, отказаться от курения. Желательно накануне не проводить лечебные процедуры.
Если индекс RDW понижен, это нередко означает необходимость в пересдаче общего анализа крови.
Расшифровка RDW в анализе крови: норма у женщин и мужчин
Показатель RDW-CV (CV – коэффициент вариации) отображает относительную ширину распределения эритроцитов по объему, т. е. насколько объем эритроцитов отличается от среднего, и измеряется в процентах. На индекс влияет показатель MCV, колебания которого приводят к увеличению RDW-CV. Норма этого показателя для взрослых мужчин и женщин составляет 11–15%. У грудничков до 6 месяцев норма RDW-CV составляет 15-19%. У детей старше 6 месяцев норма соответствует таковой для взрослых лиц.
При расшифровке RDW-SD в анализе крови (SD – стандартное отклонение) учитывается, что этот показатель не зависит от индекса MCV. Этот индекс показывает, насколько эритроциты в крови несхожи по объему и размеру, т. е. каково отличие между мелкими и крупными клетками. Норма показателя RDW-SD составляет 42±5 фл.
 Определение индекса RDW производится в ходе развернутого клинического анализа крови
Определение индекса RDW производится в ходе развернутого клинического анализа кровиПоказатель RDW-SD является более точным в случае небольшой популяции микро- или макроцитов, а индекс DW-CV точнее отображает общие изменения объема эритроцитов.
Читайте также:5 признаков возможных проблем с сердцем
15 растений, проростки семян которых стоит включить в рацион
Причины отклонения от нормы показателя RDW в анализе крови
Повышенный уровень RDW значит, что имеется неоднородность, т. е. несхожесть по объему популяции эритроцитов, а также может означать присутствие в крови нескольких популяций красных кровяных телец (например, после гемотрансфузии).
Если в анализе крови RDW-CV повышен на 15% и более, это указывает на наличие в крови разных по объему красных кровяных телец, чем выше данный индекс, тем больше разница в объеме эритроцитов. Ложно завышенный результат RDW-CV может быть обусловлен наличием в пробе крови пациента холодовых агглютининов – антител, которые вызывают агрегацию, т. е. слипание эритроцитов в случае воздействия низких температур.
Кровь для развернутого общего анализа, который включает определение эритроцитарных индексов, в том числе показателя RDW, обычно берут из вены.
Повышение RDW наблюдается при следующих патологиях:
- микроцитарные анемии;
- гемоглобинопатии;
- недостаток железа, витамина В12 и/или фолиевой кислоты в организме;
- повышение количества лейкоцитов в крови (выше 50×109/л);
- агглютинация эритроцитов;
- гемолитический криз;
- злокачественные новообразования (особенно с метастазами в костный мозг);
- миелодиспластический синдром;
- миелофиброз;
- болезнь Альцгеймера;
- сердечно-сосудистые заболевания;
- алкоголизм;
- отравление свинцом.
Повышенные значения RDW в анализе крови также могут быть получены сразу после хирургической операции или переливания крови.
Индекс остается в пределах нормы или несколько снижен при острых кровопотерях, хронических заболеваниях, гемолитической анемии вне криза, гетерозиготной бета-талассемии. Если индекс RDW понижен, это нередко означает необходимость в пересдаче общего анализа крови.
При расшифровке общего анализа крови в целом и показателя RDW в частности учитываются значения эритроцитарного индекса MCV:
- нормальное значение RDW + сниженный MCV – после переливания крови, посттравматической спленэктомии, химиотерапии, при геморрагиях, талассемии, онкологических заболеваниях;
- сниженный MCV + повышенный RDW в анализе крови – дефицит железа, фрагментация красных кровяных телец, бета-талассемия;
- повышенный MCV + нормальный RDW – при заболеваниях печени;
- повышенный MCV + повышенный RDW – при гемолитической анемии, недостатке витамина В12, присутствии в пробе крови холодовых агглютининов, а также при проведении химиотерапии.
Повышенные значения RDW в анализе крови также могут быть получены сразу после хирургической операции или переливания крови.
При получении результата показателя RDW, который выходит за пределы референсных значений, необходимы дополнительные исследования.
Видео с YouTube по теме статьи:
Об авторе

Нашли ошибку в тексте? Выделите ее и нажмите Ctrl + Enter.
Работа, которая человеку не по душе, гораздо вреднее для его психики, чем отсутствие работы вообще.
























